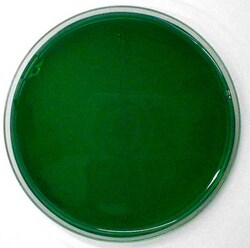
Scharlab SIMMONS CITRATE AGAR 500G, Quantity: 500g

missing translation for 'onlineSavingsMsg'
Läs mer
Läs mer
Scharlab SIMMONS CITRATE AGAR 500G
Brand: Scharlab 01-177-500
SIMMONS CITRATE AGAR 500G
Denna artikel kan inte returneras.
Se returpolicy
Korrigering av produktinnehåll
Din input är viktig för oss. Fyll i det här formuläret för att ge feedback relaterad till innehållet på denna produkt.
Produkttitel
Hittar du en möjlighet till förbättring?Dela en innehållskorrigering